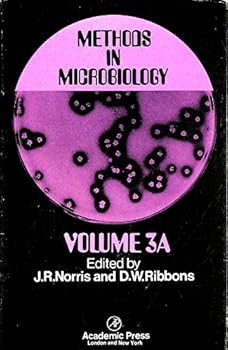
METHODS IN MICROBIOLOGY,VOLUME 3A, Volume 3A

Search page
1 - 32 of 32 results for "John R. Norris"
Selected
John R. Norris
Show Out Of Stock Items
Refine Your Search
Product Types
Genres
Formats
Conditions
Collectibles
Languages
Additional Options
Price Range
Exclude
By John R. Norris and Joann Norris

$
9.29
Save $23.21! List Price: $32.50
Format: Paperback
Condition: Very Good
![Lieutenant Govern[o]r Eben S. Draper](https://i.thriftbooks.com/api/imagehandler/m/EEA62E5509306E34B7AB1A75ABCC29B6201A4A00.jpeg)
$
16.75
Format: Paperback
Condition: New

Temporarily Unavailable
0 people are interested in this title.
We receive fewer than 1 copy every 6 months.
Temporarily Unavailable
0 people are interested in this title.
We receive fewer than 1 copy every 6 months.

Temporarily Unavailable
0 people are interested in this title.
We receive fewer than 1 copy every 6 months.

Temporarily Unavailable
0 people are interested in this title.
We receive fewer than 1 copy every 6 months.

Temporarily Unavailable
0 people are interested in this title.
We receive fewer than 1 copy every 6 months.

Temporarily Unavailable
0 people are interested in this title.
We receive fewer than 1 copy every 6 months.
By John R. Robbins and James R. Norris

Temporarily Unavailable
0 people are interested in this title.
We receive fewer than 1 copy every 6 months.

Temporarily Unavailable
0 people are interested in this title.
We receive fewer than 1 copy every 6 months.

Temporarily Unavailable
0 people are interested in this title.
We receive fewer than 1 copy every 6 months.

Temporarily Unavailable
0 people are interested in this title.
We receive fewer than 1 copy every 6 months.

$
210.00
Format: Hardcover
Condition: New

$
15.19
Save $39.81! List Price: $55.00
Format: Paperback
Condition: Acceptable

Temporarily Unavailable
0 people are interested in this title.
We receive fewer than 1 copy every 6 months.

Temporarily Unavailable
0 people are interested in this title.
We receive fewer than 1 copy every 6 months.

Temporarily Unavailable
0 people are interested in this title.
We receive fewer than 1 copy every 6 months.

$
9.19
Save $68.76! List Price: $77.95
Format: Hardcover
Condition: Like New

$
8.49
Save $161.51! List Price: $170.00
Format: Hardcover
Condition: Very Good

Temporarily Unavailable
0 people are interested in this title.
We receive fewer than 1 copy every 6 months.

Temporarily Unavailable
0 people are interested in this title.
We receive fewer than 1 copy every 6 months.

Temporarily Unavailable
0 people are interested in this title.
We receive fewer than 1 copy every 6 months.

$
19.50
Format: Paperback
Condition: New

$
4.99
Save $0.01! List Price: $5.00
Format: Paperback
Condition: Very Good

Temporarily Unavailable
0 people are interested in this title.
We receive fewer than 1 copy every 6 months.

$
12.36
Format: Paperback
Condition: New

$
9.91
Format: Paperback
Condition: New

Temporarily Unavailable
0 people are interested in this title.
We receive fewer than 1 copy every 6 months.

$
14.59
Save $2.36! List Price: $16.95
Format: Paperback
Condition: Good

$
4.79
Save $3.16! List Price: $7.95
Format: Paperback
Condition: Very Good

Temporarily Unavailable
25 people are interested in this title.
We receive fewer than 1 copy every 6 months.
Issues with your search? so we can make it easier for you to find products.
If you have order questions or need additional assistance, please visit Help & Support.




